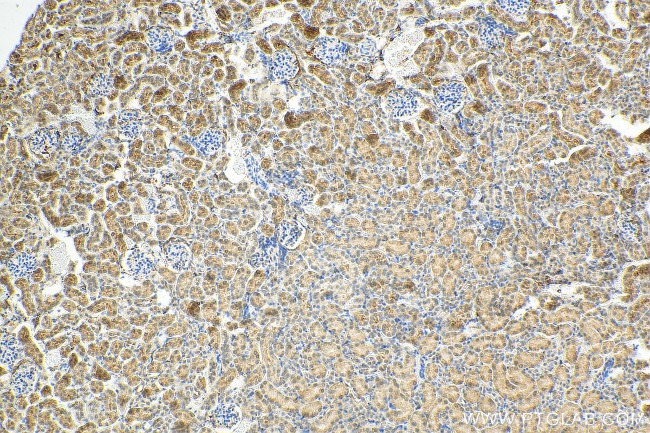
RANBP3L Antibody in Immunohistochemistry (Paraffin) (IHC (P))

Search
Proteintech
RANBP3L Polyclonal Antibody
{{$productOrderCtrl.translations['antibody.pdp.commerceCard.promotion.promotions']}}
{{$productOrderCtrl.translations['antibody.pdp.commerceCard.promotion.viewpromo']}}
{{$productOrderCtrl.translations['antibody.pdp.commerceCard.promotion.promocode']}}: {{promo.promoCode}} {{promo.promoTitle}} {{promo.promoDescription}}. {{$productOrderCtrl.translations['antibody.pdp.commerceCard.promotion.learnmore']}}
产品信息
17875-1-AP
种属反应
宿主/亚型
分类
类型
抗原
偶联物
形式
浓度
规格
纯化类型
保存液
内含物
保存条件
运输条件
产品详细信息
Immunogen sequence: SAEQGPVKH SKHVIRPAIL QLPQARSCAK VRKTFGHKAL ESCKTKEKTN NKISEGNSYL LSENLSRARI SVQLSTNQDF LGATSVGCQP NEDKCSFKSC SSNFVFGENM VERVLGTQKL TQPQLENDSY AKEKPFKSIP KFPVNFLSSR TDSIKNTSLI ESAAAFSSQP SRKCLLEKID VITGEETEHN VLKINCKLFI FNKTTQSWIE RGRGTLRLND TASTDCGTLQ SRLIMRNQGS LRLILNSKLW AQMKIQRANH KNVRITATDL EDYSIKIFLI QASAQDTAYL YAAIHHRLVA LQSFNKQRDV NQAESLSETA QQLNCESCDE NEDDFIQVTK NGSDPSSWTH RQSVACS (110-465 aa encoded by BC047660 )
仅用于科研。不用于诊断过程。未经明确授权不得转售。
篇参考文献 (0)
生物信息学
蛋白别名: Ran-binding protein 3-like; unnamed protein product
基因别名: C130037N17Rik; RANBP3L
UniProt ID: (Human) Q86VV4, (Mouse) Q6PDH4
Entrez Gene ID: (Human) 202151, (Mouse) 223332